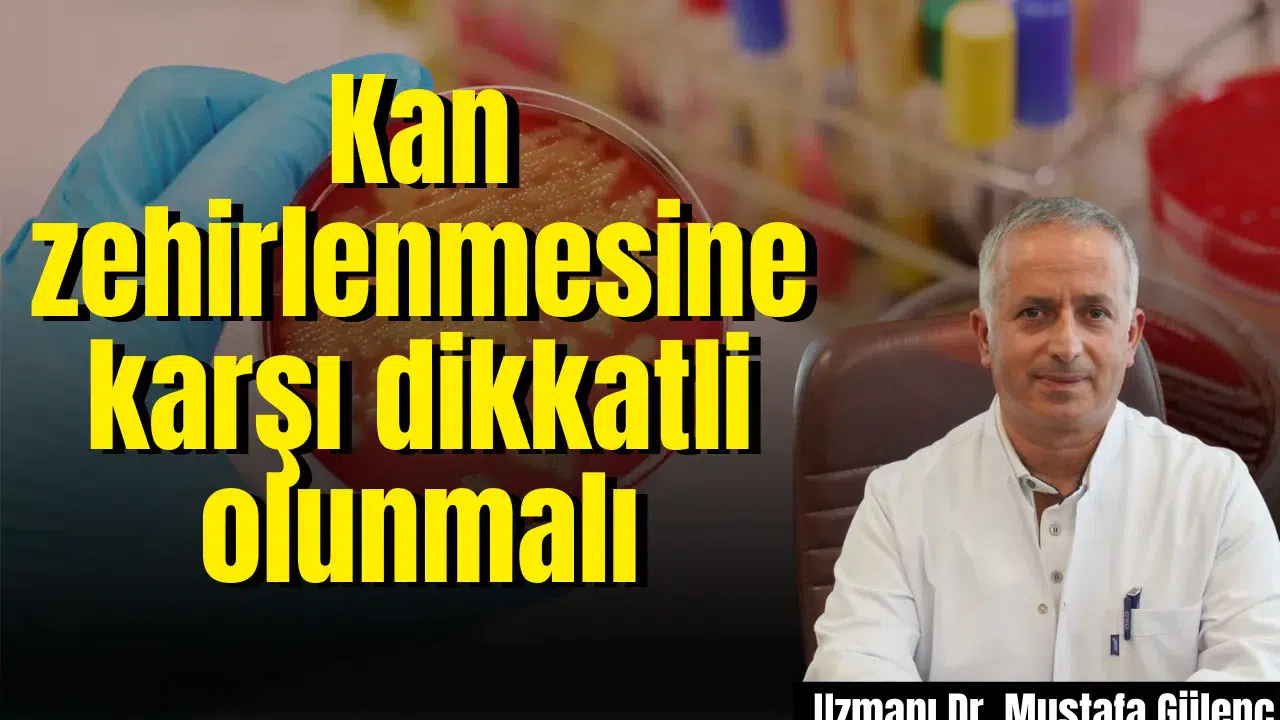
Kan zehirlenmesine karşı dikkatli olunmalı

Haber Detayı
Kan zehirlenmesine karşı dikkatli olunmalı
Manisa Özel Grandmedical Hastanesi Enfeksiyon Hastalıkları Uzmanı Dr. Mustafa Gülenç, “kan zehirlenmesi” olarak adlandırılan sepsisin toplumda yeterince bilinmeyen ancak ölümcül sonuçlara yol açabilen bir sağlık sorunu olduğunu belirtti. Gülenç, “Sepsis özellikle bağışıklık sistemi zayıf olan bireyler, yaşlılar, bebekler ve kronik hastalığı olanlar için büyük bir risk oluşturur” dedi.
Manisa Özel Grandmedical Hastanesi Enfeksiyon Hastalıkları Uzmanı Dr.Mustafa Gülenç, “kan zehirlenmesi” olarak adlandırılan sepsisin toplumda yeterince bilinmeyen ancak ölümcül sonuçlara yol açabilen …






















































